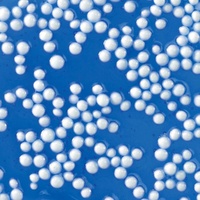

Putty that crackles, pops, and snaps!
Crackle’n Kraken’s blue putty can fare the seas and includes tentacle-like beads. Perfect your popping techniques to hear mythical monster sounds. The “poppabilities” are endless!
Thinking Putty helps build hand and finger strength through a fabulous tactile play experience with unique, unexpected properties and provides relaxing, yet stimulating interaction for anyone with sensory integration issues. Thinking Putty is non-toxic, won't dry out, and won't leave a sticky or slippery residue on your fingers, so it's great for stretching, moulding, bouncing, tearing, popping and playing by kids and adults alike.
Ages: 3+
Made in the USA
(KK020)
| SKU | KK020 |
| Barcode # | 810066953680 |
| Brand | Crazy Aaron's |
| Shipping Weight | 0.1700kg |